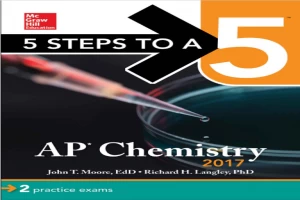

Newly released
This book is new and will be uploaded as soon as it becomes available to us and if we secure the necessary publishing rights.
AP Chemistry 2017 Book PDF
(0)
Author:
John MooreNumber Of Reads:
205
Language:
English
Category:
Natural ScienceSection:
Pages:
599
Quality:
good
Views:
1406
Quate
Review
Save
Share
New
Book Description
Get ready for your AP Chemistry exam with this straightforward, easy-to-follow study guide--updated to match the latest test changes
The wildly popular test prep guide— updated and enhanced for smartphone users—5 Steps to a 5: AP Chemistry 2017 provides a proven strategy to achieving high scores on this demanding Advanced Placement exam.
This logical and easy-to-follow instructional guide introduces an effective 5-step study plan to help students build the skills, knowledge, and test-taking confidence they need to reach their full potential. One of the most demanding AP tests, the Chemistry exam includes multiple-choice questions, experiment-based questions, and free-response questions that require students to supply original worked-out solutions. 5 Steps to a 5: AP Chemistry 2017 helps students master all question types and offers comprehensive answer explanations and sample responses. Written by two Chemistry professors, this insider’s guide reflects the latest course syllabus and includes 2 full-length practice exams that match the latest version of the exam.
The 5 Steps to a 5: AP Chemistry 2017 effective 5-step plan breaks down test preparation into stages: 1. Set Up Your Study Program 2. Determine Your Test Readiness 3. Develop Strategies for Success 4. Develop the Knowledge You Need to Score High 5. Build Your Test-Taking Confidence.
2 full-length practice exams
· BONUS interactive AP Planner app delivers a customized study schedule and extra practice questions to students’ mobile devices
· The 5 Steps to a 5 series has prepared millions of students for success
John Moore
John Moore grew up in the foothills of Western North Carolina. He attended the University of North Carolina -Asheville where he received his bachelor's degree in chemistry. He earned his Master's degree in chemistry from Furman University in Greenville, South Carolina. After a stint in the United States Army he decided to try his hand at teaching. In 1971, he joined the chemistry faculty of Stephen F. Austin State University in Nacogdoches, Texas where he still teaches chemistry. In 1985 he started back to school part time and in 1991 received his Doctorate in Education from Texas A&M University.
John's area of specialty is chemical education, especially at the pre-high school level. He has been the co-editor (along with one of his former students) of the Chemistry for Kids feature of The Journal of Chemical Education. He has authored numerous chemistry books including Chemistry for Dummies, Chemistry Made Simple,Chemistry for the Utterly Confused and Biochemistry for Dummies. He is currently working on a college textbook.
John lives in Nacogdoches, Texas with his wife Robin and their two dogs and two cats. He enjoys brewing his own beer and mead and working with wood. Lately he has been creating custom knife handles and pens from exotic woods. And he loves to cook. His two boys, Jason and Matt, remain in the mountains of North Carolina along with his wonderful twin grandbabies, Sadie and Zane, and his fabulous daughter-in-law Sara.
Read More
Book Currently Unavailable
This book is currently unavailable for publication. We obtained it under a Creative Commons license, but the author or publisher has not granted permission to publish it.
Rate Now
5 Stars
4 Stars
3 Stars
2 Stars
1 Stars
AP Chemistry 2017 Quotes
Top Rated
Latest
Quate
Be the first to leave a quote and earn 10 points
instead of 3
Comments
Be the first to leave a comment and earn 5 points
instead of 3